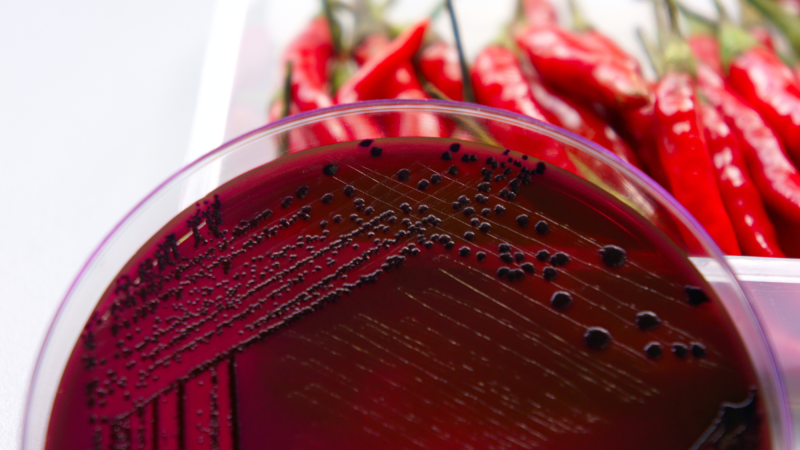
Food safety

Grower support
Growers are encouraged to get in contact with the Rural Support Trust who are the lead agency that provide on the ground support. Phone: 0800 787 254 or visit their website here.
The Ministry for Primary Industries (MPI) have information and resources available to help you deal with floods - you can access these here.
Please utilise the list of support, resources, links and grower guidance below. If you have a specific query or require further assistance, please don't hesitate to contact info@hortnz.co.nz.